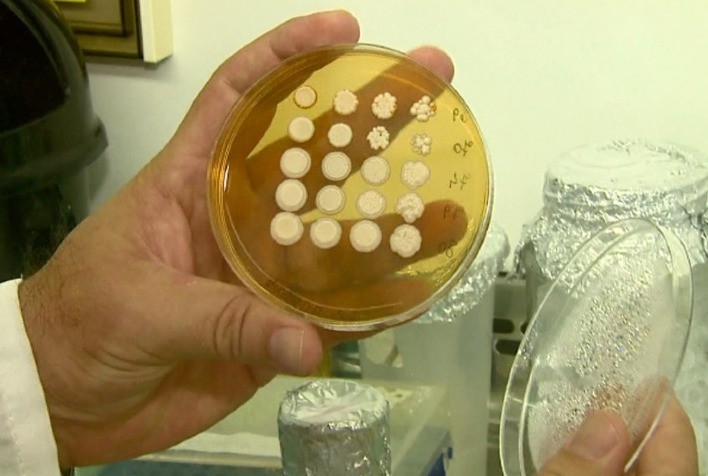
Ministério da Agricultura libera novo fungicida microbiológico da Rizobacter

Ministério da Agricultura libera novo fungicida microbiológico da Rizobacter
Rizoderma é um produto com formulação 100% líquida e composto por um fungo chamado Trichoderma afroharzianum, já ativo na embalagem, acelerando o tratamento contra doenças no solo e na semente, em diversas culturas, como soja, trigo, arroz e milho. Inovador produto foi fruto de pesquisas desenvolvidas durante dez anos
Publicado em: 14/01/2022 às 15:00hs
A Rizobacter, multinacional líder em microbiologia agrícola, traz mais uma solução inovadora e sustentável para a agricultura brasileira, o Rizoderma TSI -- um fungicida microbiológico composto por um fungo ainda inédito no mercado brasileiro, o Trichoderma afroharzianum, que traz uma nova ferramenta ao mercado brasileiro para o combate das doenças do solo e da semente, em culturas de grande interesse econômico do mercado mundial como soja, trigo, arroz, milho, entre outras. O produto foi aprovado no último mês pelo Departamento de Sanidade Vegetal e Insumos Agrícolas da Secretaria de Defesa Agropecuária, do Ministério da Agricultura e Pecuária (MAPA).
O Rizoderma foi desenvolvido no centro de pesquisa e desenvolvimento global da Rizobacter, na Argentina, em pesquisas e desenvolvimentos que duraram dez anos. É considerado a 3ª geração de produtos biológicos, pois é produzido na forma líquida. Sua formulação fluída garante uma maior aplicabilidade no tratamento de sementes de uma forma geral, além disso, permite que as células fúngicas sejam mais estáveis e com maior poder fungicida, o que significa maior proteção no campo. Desta maneira, atua mais rápido colonizando a raiz da planta, que terá a produção de metabolitos secundários, entre eles os antibióticos, que vão inibir ou matar outros fungos, além de produzir fito hormônios, que são responsáveis pelo crescimento e metabolismo vegetal.
“De maneira didática, o Rizoderma consegue fazer com que a planta cresça mais rápido, de forma protegida e produzindo na raiz mais ácidos orgânicos. Esses, por sua vez, disponibilizam nutrientes que são absorvidos do solo”, destaca Lucas Lopes, gerente de produto da linha de Controle Biológico e Tratamento de Sementes e Grãos da Rizobacter.
Sendo um fungicida microbiológico, a inovação da Rizobacter combina múltiplos mecanismos de ação que naturalmente previnem e retardam as possibilidades de desenvolvimento e ataque de patógenos. As biomoléculas produzidas são absorvidas e ativam os mecanismos fisiológicos e bioquímicos de defesa na planta e, assim, dão maior tempo de proteção durante todas as fases de crescimento da cultura. Outro diferencial do Rizoderma é o fungo já estar ativo dentro da embalagem. Uma vez aplicado, já entra em ação e consegue uma maior eficiência e melhores resultados comparados com os produtos em que o fungo está inativo.
"É uma grande conquista para a Rizobacter trazer o Rizoderma ao Brasil. A empresa já é líder no tratamento industrial de sementes de soja no país, com mais de 5 milhões de hectares cobertos por nossos inoculantes e, agora, passa a ter mais uma ferramenta fundamental, para um programa de nutrição e proteção, com a nova solução. Acreditamos que, hoje, seja o produto mais completo, sustentável e tecnológico do mercado", diz Lopes.
Resultado comprovado
O Rizoderma tem comprovado sua eficácia no controle de múltiplas doenças de sementes e solo, como Sclerotinia sclerotiorum (mofo branco), macrophomina, fusarium, rizoctonia, que afetam a germinação e o desenvolvimento inicial de culturas como milho, soja e trigo. “Graças ao processo de fermentação líquida de alta qualidade, o Rizoderma pode ser aplicado com mais de 90 dias de antecedência na semente”, finaliza Lopes.
Fonte: CDI Comunicação
◄ Leia outras notícias